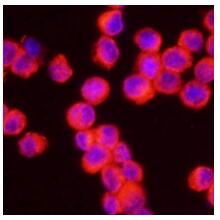

Product Name :
NLRP3 polyclonal antibody Background :
This gene encodes a pyrin-like protein containing a pyrin domain, a nucleotide-binding site (NBS) domain, and a leucine-rich repeat (LRR) motif. This protein interacts with the apoptosis-associated speck-like protein PYCARD/ASC, which contains a caspase recruitment domain, and is a member of the NALP3 inflammasome complex. This complex functions as an upstream activator of NF-kappaB signaling, and it plays a role in the regulation of inflammation, the immune response, and apoptosis. Mutations in this gene are associated with familial cold autoinflammatory syndrome (FCAS), Muckle-Wells syndrome (MWS), chronic infantile neurological cutaneous and articular (CINCA) syndrome, and neonatal-onset multisystem inflammatory disease (NOMID). Multiple alternatively spliced transcript variants encoding distinct isoforms have been identified for this gene. Alternative 5' UTR structures are suggested by available data; however, insufficient evidence is available to determine if all of the represented 5' UTR splice patterns are biologically valid. Product :
1mg/ml in PBS with 0.02% sodium azide, 50% glycerol, pH7.2 Storage&Stability :
Store at 4°C short term. Aliquot and store at -20°C long term. Avoid freeze-thaw cycles. Specificity :
NLRP3 polyclonal antibody detects endogenous levels of NLRP3 protein. Immunogen :
Recombinant protein of human NLRP3. Conjugate :
Unconjugated Modification :
Unmodified
NLRP3 polyclonal antibody Background :
This gene encodes a pyrin-like protein containing a pyrin domain, a nucleotide-binding site (NBS) domain, and a leucine-rich repeat (LRR) motif. This protein interacts with the apoptosis-associated speck-like protein PYCARD/ASC, which contains a caspase recruitment domain, and is a member of the NALP3 inflammasome complex. This complex functions as an upstream activator of NF-kappaB signaling, and it plays a role in the regulation of inflammation, the immune response, and apoptosis. Mutations in this gene are associated with familial cold autoinflammatory syndrome (FCAS), Muckle-Wells syndrome (MWS), chronic infantile neurological cutaneous and articular (CINCA) syndrome, and neonatal-onset multisystem inflammatory disease (NOMID). Multiple alternatively spliced transcript variants encoding distinct isoforms have been identified for this gene. Alternative 5' UTR structures are suggested by available data; however, insufficient evidence is available to determine if all of the represented 5' UTR splice patterns are biologically valid. Product :
1mg/ml in PBS with 0.02% sodium azide, 50% glycerol, pH7.2 Storage&Stability :
Store at 4°C short term. Aliquot and store at -20°C long term. Avoid freeze-thaw cycles. Specificity :
NLRP3 polyclonal antibody detects endogenous levels of NLRP3 protein. Immunogen :
Recombinant protein of human NLRP3. Conjugate :
Unconjugated Modification :
Unmodified
-
 Western blot analysis of NLRP3 expression in HT29 (A), mouse brain (B), rat brain (C) whole cell lysates.
Western blot analysis of NLRP3 expression in HT29 (A), mouse brain (B), rat brain (C) whole cell lysates. -
 Immunohistochemical analysis of NLRP3 staining in mouse spleen formalin fixed paraffin embedded tissue section.
Immunohistochemical analysis of NLRP3 staining in mouse spleen formalin fixed paraffin embedded tissue section. -
Immunohistochemical analysis of NLRP3 staining in mouse spleen formalin fixed paraffin embedded tissue section.
Immunohistochemical analysis of NLRP3 staining in mouse spleen formalin fixed paraffin embedded tissue section.
Human amniotic mesenchymal stem cell-conditioned medium inhibited LPS-induced cell injury and inflammation by modulating CD14/TLR4-mediated signaling pathway in monocytes
PMCID: Pubmed No.:37087900
Hydrogen-Rich Saline—A Novel Neuroprotective Agent in a Mouse Model of Experimental Cerebral Ischemia via the ROS-NLRP3 Inflammasome Signaling Pathway In Vivo and In Vitro
PMCID: Pubmed No.:37371417
Bioworld Biotech only provide peptides for our antibodies and do not provide additional peptide customization services.
Price/Size :
USD 368/1mg/vial
Tips:
For phospho antibody, we provide phospho peptide(0.5mg) and non-phospho peptide(0.5mg).Describe :
Blocking peptides are peptides that bind specifically to the target antibody and block antibody binding. These peptide usually contains the epitope recognized by the antibody. Antibodies bound to the blocking peptide no longer bind to the epitope on the target protein. This mechanism is useful when non-specific binding is an issue, for example, in Western blotting (WB) and Immunohistochemistry (IHC). By comparing the staining from the blocked antibody versus the antibody alone, one can see which staining is specific; Specific binding will be absent from the western blot or IHC performed with the neutralized antibody.Formula:
Synthetic peptide was lyophilized with 100% acetonitrile and is supplied as a powder. Reconstitute with 0.1 ml DI water for a final concentration of 10 mg/ml.The purity is >90%,tested by HPLC and MS.
Storage:
The freeze-dried powder is more stable. For short time at 2-8°C. For long term storage store at -20°C.
Note :
This product is for research use only (RUO only). Not for use in diagnostic or therapeutic procedures.
 NLRP3 polyclonal antibody
NLRP3 polyclonal antibody  Datasheet
Datasheet COA
COA MSDS
MSDS SHIP
SHIP